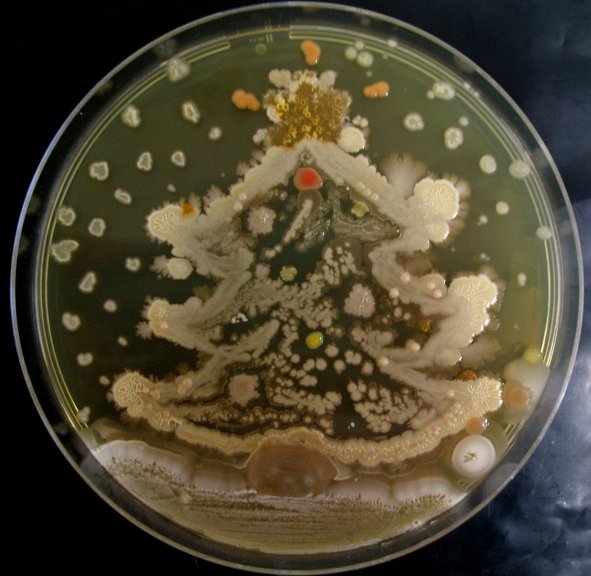

ಟ್ವೀಟ್ಗಳು
- ಟ್ವೀಟ್ಗಳು
- ಟ್ವೀಟ್ಗಳು & ಪ್ರತಿಕ್ರಿಯೆಗಳು
- ಮಾಧ್ಯಮ
@SciStarter ತಡೆಹಿಡಿಯಲಾಗಿದೆ
ನೀವು ಖಚಿತವಾಗಿಯೂ ಈ ಟ್ವೀಟ್ಗಳನ್ನು ನೋಡಲು ಬಯಸುವಿರಾ? ಟ್ವೀಟ್ಗಳನ್ನು ನೋಡುವುದು @SciStarter ಅವರನ್ನು ತಡೆತೆರವುಗೊಳಿಸುವುದಿಲ್ಲ.
-
ಪಿನ್ ಮಾಡಿದ ಟ್ವೀಟ್
SciStarter's first-ever gift guide is here! Find the perfect gift for the
#citizenscience enthusiast in your life! http://bit.ly/2gD8rPE pic.twitter.com/Y2FmxCynDC
-
Wishing you a happy and safe holiday from SciStarter!pic.twitter.com/SzxiwsVaWI

-
On the 12th Day of Christmas
@CyanoMon gave to me: 12 drummers monitoring blue green algal blooms: https://shar.es/1DvLoy#citizensciencepic.twitter.com/xH2nQMxklG
-
On the 11th Day of Christmas
@openstreetmap gave to me: 11 pipers piping as I mapped the streets in my city: https://shar.es/1DvN4B#citscipic.twitter.com/Qrq1eSSt82
-
Need last minute gift ideas? We have you covered!

 https://twitter.com/SciStarter/status/803368395597029377 …
https://twitter.com/SciStarter/status/803368395597029377 …
-
Happy Holidays! 12 Days of Christmas with
#CitizenScience countdown: http://bit.ly/2hcutHV@DiscoverMag#citscipic.twitter.com/D1m7G0jApO -
Sure thing! Check out
@FreshWaterWatch &@MonitorWater & and more: http://scistarter.com/finder Happy Sampling! :)https://twitter.com/SecchiDipIn/status/812710153460060160 … -
On the 10th Day of Christmas
@ColonyBgame gave2me:10 lordsa-leaping at the chance to study microbes: https://shar.es/1DvynV#citizensciencepic.twitter.com/QNKYObO1nF
-
Join other citizen scientists to advance research in your own backyard or around the world via
@SciStarter http://scistarter.com/#MTedchat -
On the 9th Day of Christmas, Project Implicit gave to me: nine ladies dancing with glee as they..https://shar.es/1Dvkt0
#citizensciencepic.twitter.com/Kva1isjQ8n
-
On the 8th Day of Christmas
@milkywayproj gave2me: 8 maids-a-milking in a beautiful image of faraway space: https://shar.es/1DvABg#citscipic.twitter.com/y00xOPB4bl
-
On the 7th Day of Christmas Lake Observer gave2me: 7 swans-a-swimming in a lake while I monitored..: https://shar.es/1DvAGU
#citizensciencepic.twitter.com/q3xyNNY4tO
-
Scientists could learn an important lesson from Trump’s victory: http://www.slate.com/articles/technology/future_tense/2016/12/trump_s_victory_shows_that_scientists_need_to_engage_more_with_the_public.html?wpsrc=sh_all_mob_tw_top … via
@slate#citizenscience -
On the 6th Day of Christmas
@MyAirVisual gave to me: https://shar.es/1DtqDW#citizensciencepic.twitter.com/V3WPWjckjn
-
SciStarter ಹಿಂಬಾಲಿಸಿದ್ದಾರೆ Crowd Informatics ಮತ್ತು AirVisual
-
@CrowdInfomatic
Consulting for citizen science and crowd sourcing projects, from project development to project outcome assessments. Founder
@HeatherAFischer -
@MyAirVisual
A community driving air quality awareness through no-nonsense information and access to live and forecast air quality data. https://airvisual.com/node
-
-
On the 5th Day of Christmas, the Golden Eagle Survey Project gave to me: 5 gold rings as bright as the feathers..: https://shar.es/1DtqCC pic.twitter.com/rHIPIAfuri

-
On the 4th Day of Christmas
@lingscape gave to me: 4 calling birds perched on street signs: https://shar.es/1Dt2Nl#citizensciencepic.twitter.com/Psh9ai8dDz
-
#CitizenScience + photos of signs in public spaces = literacy and spatial awareness with@lingscape http://nstacommunities.org/blog/2016/12/23/citizen-science-photos-of-signs-in-public-spaces-literacy-and-spatial-awareness/ …#NSTA#citsciedu -
Tis the season - The annual Wintering
#GoldenEagle Survey is here! Sign up with@SciStarter http://bit.ly/2h6Wtwv#CitSci -
Citizen Science Maker Summit highlights video: https://www.youtube.com/watch?v=o5k6vXMdaO4&sns=tw …
@PublicLab@USGS@SciStarter@ASU_SFIS@micahlande@NASAJPL -
12 Days of Christmas with
#CitizenScience (seriously!) https://shar.es/1D2dgZ#citscipic.twitter.com/VycvqIxurU
ಲೋಡಿಂಗ್ ಸಮಯ ಸ್ವಲ್ಪ ತೆಗೆದುಕೊಳ್ಳುತ್ತಿರುವಂತೆನಿಸುತ್ತದೆ.
Twitter ಸಾಮರ್ಥ್ಯ ಮೀರಿರಬಹುದು ಅಥವಾ ಕ್ಷಣಿಕವಾದ ತೊಂದರೆಯನ್ನು ಅನುಭವಿಸುತ್ತಿರಬಹುದು. ಮತ್ತೆ ಪ್ರಯತ್ನಿಸಿ ಅಥವಾ ಹೆಚ್ಚಿನ ಮಾಹಿತಿಗೆ Twitter ಸ್ಥಿತಿಗೆ ಭೇಟಿ ನೀಡಿ.


 SciStarter
SciStarter
 Jessica Anderson
Jessica Anderson


 TheCrowd&TheCloud
TheCrowd&TheCloud
 Darlene Cavalier
Darlene Cavalier